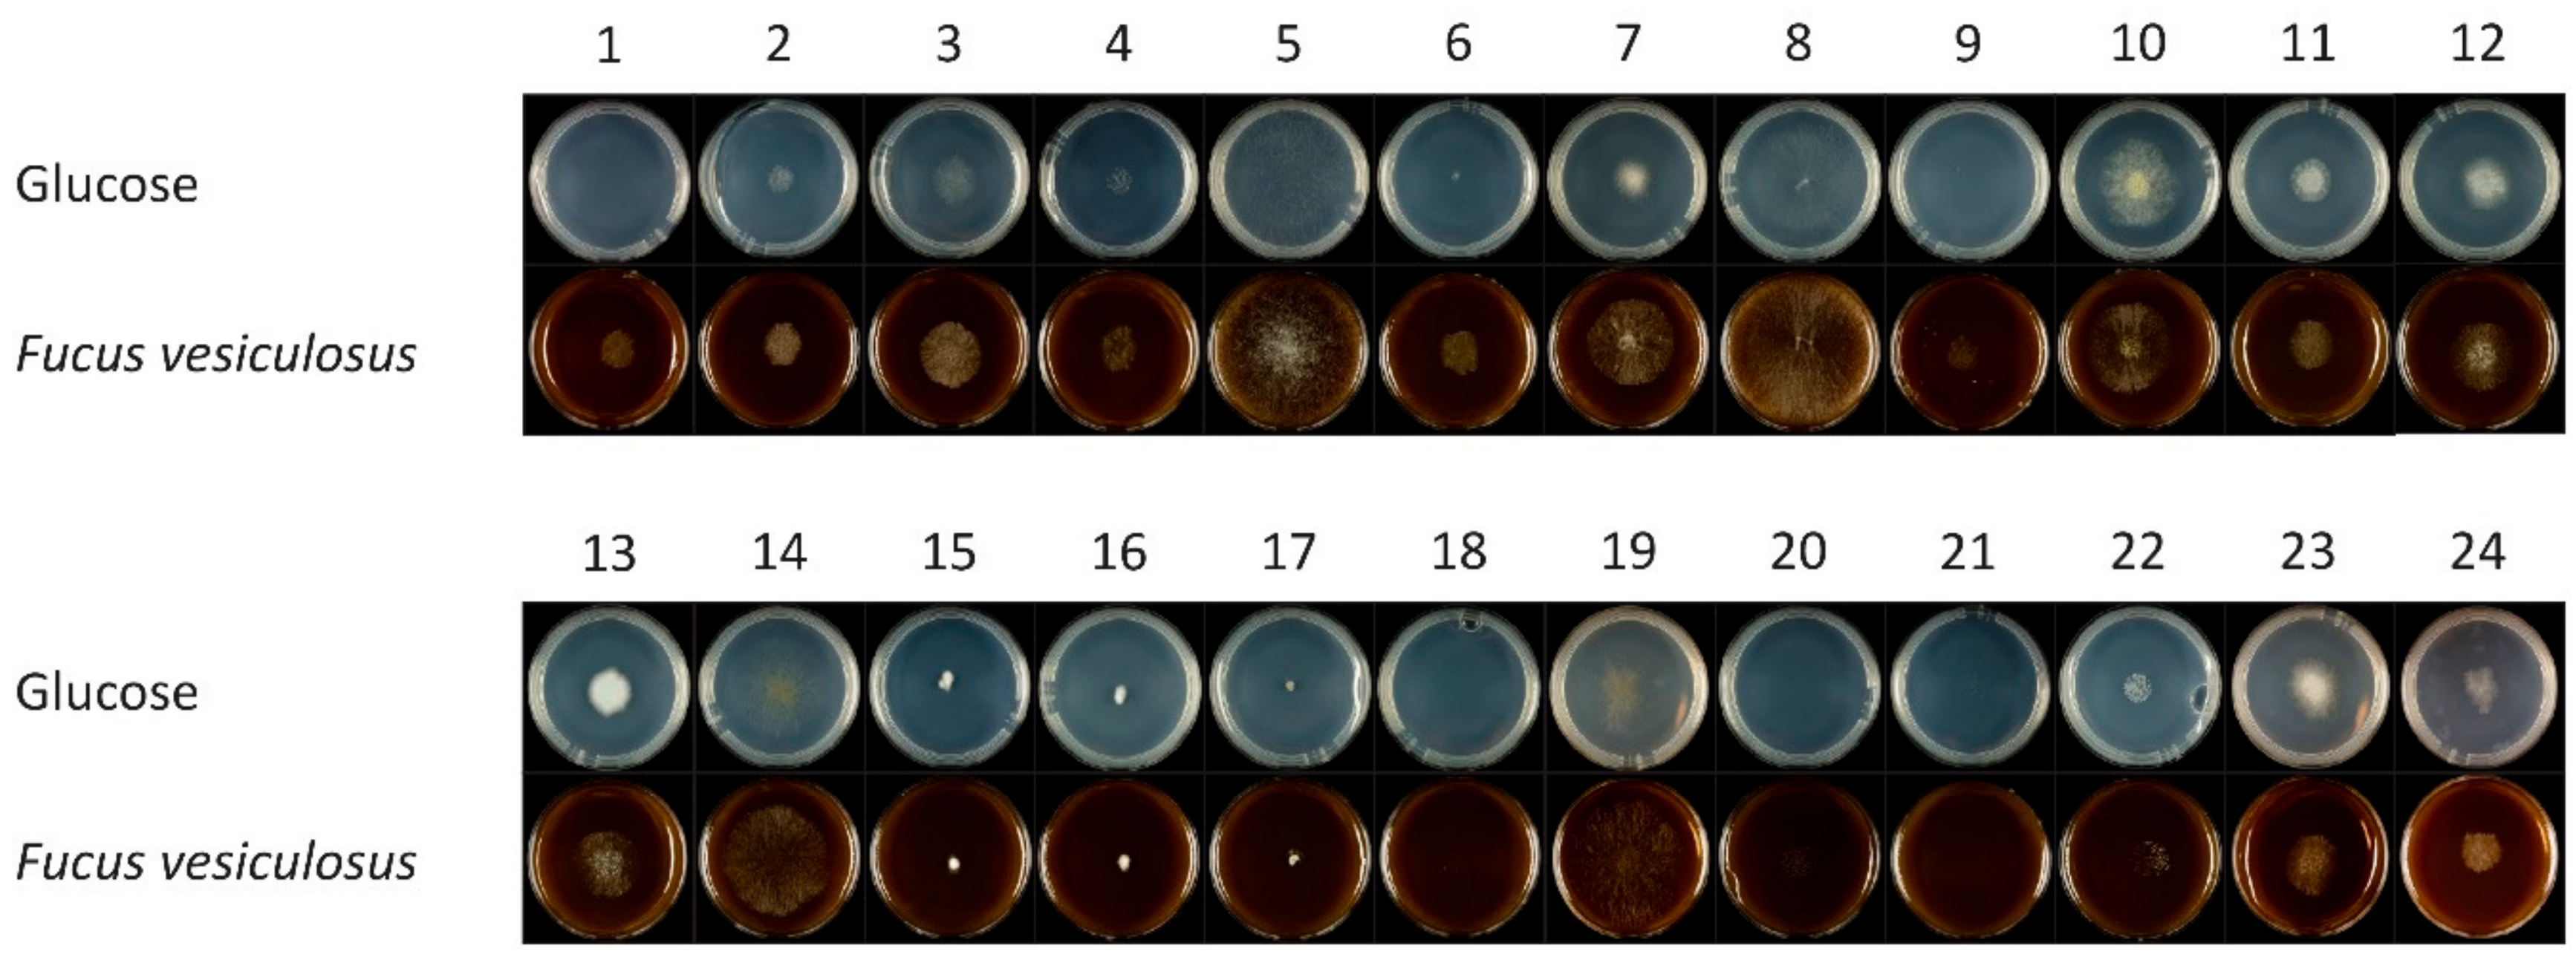
Microorganisms 08 00052 g001 Microorganisms 08 00052 g001

Macroalgae Derived Fungi Have High Abilities to Degrade Algal Polymers
Abstract
1. Introduction
2. Materials and Methods
2.1. Materials and Culture Conditions
2.2. Growth and Utilization of Algal Carbon Sources
2.3. DNA Extraction, PCR Amplification and Sequencing
2.4. Enzyme Assays
3. Results
3.1. Identification of the Fungal Isolates from Fucus sp.
3.2. Growth and Utilization of Algal Carbon Sources
3.3. Enzyme Activities during Growth on Seaweed and Plant Biomass Substrates
4. Discussion
Author Contributions
Funding
Acknowledgments
Conflicts of Interest
References
- Masarin, F.; Cedeno, F.R.; Chavez, E.G.; de Oliveira, L.E.; Gelli, V.C.; Monti, R. Chemical analysis and biorefinery of red algae Kappaphycus alvarezii for efficient production of glucose from residue of carrageenan extraction process. Biotechnol. Biofuels 2016, 9, 1–12. [Google Scholar] [CrossRef] [PubMed]
- Rodrigues, D.; Sousa, S.; Silva, A.; Amorim, M.; Pereira, L.; Rocha-Santos, T.A.P.; Gomes, A.M.P.; Duarte, A.C.; Freitas, A.C. Impact of enzyme- and ultrasound-assisted extraction methods on biological properties of red, brown, and green seaweeds from the central west coast of Portugal. J. Agric. Food Chem. 2015, 63, 3177–3188. [Google Scholar] [CrossRef] [PubMed]
- Maehre, H.K.; Jensen, I.J.; Eilertsen, K.E. Enzymatic pre-treatment increases the protein bioaccessibility and extractability in dulse (Palmaria palmata). Mar. Drugs 2016, 14, 196. [Google Scholar] [CrossRef] [PubMed]
- Deniaud-Bouët, E.; Hardouin, K.; Potin, P.; Kloareg, B.; Hervé, C. A review about brown algal cell walls and fucose-containing sulfated polysaccharides: Cell wall context, biomedical properties and key research challenges. Carbohydr. Polym. 2017, 175, 395–408. [Google Scholar] [CrossRef]
- Lahaye, M.; Robic, A. Structure and functional properties of ulvan, a polysaccharide from green seaweeds. Biomacromolecules 2007, 8, 1765–1774. [Google Scholar] [CrossRef]
- Jiménez-Escrig, A.; Gómez-Ordóñez, E.; Rupérez, P. Infrared characterisation, monosaccharide profile and antioxidant activity of chemical fractionated polysaccharides from the edible seaweed sugar Kombu (Saccharina latissima). Int. J. Food Sci. Technol. 2015, 50, 340–346. [Google Scholar] [CrossRef]
- Kloareg, B.; Quatrano, R. Structure of the cell walls of marine algae and ecophysiological functions of the matrix polysaccharides. Oceanogr. Mar. Biol. 1988, 26, 259–315. [Google Scholar]
- Zhang, X.; Thomsen, M. Biomolecular composition and revenue explained by interactions between extrinsic factors and endogenous rhythms of Saccharina latissima. Mar. Drugs 2019, 17, 107. [Google Scholar] [CrossRef]
- Fiset, C.; Irwin, A.J.; Finkel, Z.V. The macromolecular composition of noncalcified marine macroalgae. J. Phycol. 2019, 55, 1361–1369. [Google Scholar] [CrossRef]
- Abdel-Fattah, A.; Edrees, M. Seasonal changes in the constituents of Ulva lactuca. Phytochemistry 1973, 12, 481–485. [Google Scholar] [CrossRef]
- Khairy, H.M.; El-Shafay, S.M. Seasonal variations in the biochemical composition of some common seaweed species from the coast of Abu Qir Bay, Alexandria, Egypt. Oceanologia 2013, 55, 435–452. [Google Scholar] [CrossRef]
- Schiener, P.; Black, K.D.; Stanley, M.S.; Green, D.H. The seasonal variation in the chemical composition of the kelp species Laminaria digitata, Laminaria hyperborea, Saccharina latissima and Alaria esculenta. J. Appl. Phycol. 2015, 27, 363–373. [Google Scholar] [CrossRef]
- Manns, D.; Nielsen, M.M.; Bruhn, A.; Saake, B.; Meyer, A.S. Compositional variations of brown seaweeds Laminaria digitata and Saccharina latissima in Danish waters. J. Appl. Phycol. 2017, 29, 1493–1506. [Google Scholar] [CrossRef]
- Vermaas, J.V.; Petridis, L.; Qi, X.; Schulz, R.; Lindner, B.; Smith, J.C. Mechanism of lignin inhibition of enzymatic biomass deconstruction. Biotechnol. Biofuels 2015, 8, 1–16. [Google Scholar] [CrossRef] [PubMed]
- Studer, M.H.; DeMartini, J.D.; Davis, M.F.; Sykes, R.W.; Davison, B.; Keller, M.; Tuskan, G.A.; Wyman, C.E. Lignin content in natural Populus variants affects sugar release. Proc. Natl. Acad. Sci. USA 2011, 108, 6300–6305. [Google Scholar] [CrossRef]
- Si, S.; Chen, Y.; Fan, C.; Hu, H.; Li, Y.; Huang, J.; Liao, H.; Hao, B.; Li, Q.; Peng, L.; et al. Lignin extraction distinctively enhances biomass enzymatic saccharification in hemicelluloses-rich Miscanthus species under various alkali and acid pretreatments. Bioresour. Technol. 2015, 183, 248–254. [Google Scholar] [CrossRef]
- Barbarino, E.; Lourenço, S.O. An evaluation of methods for extraction and quantification of protein from marine macro- and microalgae. J. Appl. Phycol. 2005, 17, 447–460. [Google Scholar] [CrossRef]
- Harnedy, P.A.; FitzGerald, R.J. Extraction of protein from the macroalga Palmaria palmata. LWT-Food Sci. Technol. 2013, 51, 375–382. [Google Scholar] [CrossRef]
- Polikovsky, M.; Fernand, F.; Sack, M.; Frey, W.; Müller, G.; Golberg, A. Towards marine biorefineries: Selective proteins extractions from marine macroalgae Ulva with pulsed electric fields. Innov. Food Sci. Emerg. Technol. 2016, 37, 194–200. [Google Scholar] [CrossRef]
- Hardouin, K.; Bedoux, G.; Burlot, A.-S.; Donnay-Moreno, C.; Bergé, J.-P.; Nyvall-Collén, P.; Bourgougnon, N. Enzyme-assisted extraction (EAE) for the production of antiviral and antioxidant extracts from the green seaweed Ulva armoricana (Ulvales, Ulvophyceae). Algal Res. 2016, 16, 233–239. [Google Scholar] [CrossRef]
- Charoensiddhi, S.; Franco, C.; Su, P.; Zhang, W. Improved antioxidant activities of brown seaweed Ecklonia radiata extracts prepared by microwave-assisted enzymatic extraction. J. Appl. Phycol. 2015, 27, 2049–2058. [Google Scholar] [CrossRef]
- Tisthammer, K.H.; Cobian, G.M.; Amend, A.S. Global biogeography of marine fungi is shaped by the environment. Fungal Ecol. 2016, 19, 39–46. [Google Scholar] [CrossRef]
- Raghukumar, S. The marine environment and the role of fungi. In Fungi in Coastal and Oceanic Marine Ecosystems: Marine Fungi; Springer International Publishing: Cham, Switzerland, 2017; pp. 17–38. [Google Scholar] [CrossRef]
- Jones, E.B.G.; Suetrong, S.; Sakayaroj, J.; Bahkali, A.H.; Abdel-Wahab, M.A.; Boekhout, T.; Pang, K.-L. Classification of marine Ascomycota, Basidiomycota, Blastocladiomycota and Chytridiomycota. Fungal Divers. 2015, 73, 1–72. [Google Scholar] [CrossRef]
- Debbab, A.; Aly, A.H.; Proksch, P. Mangrove derived fungal endophytes–a chemical and biological perception. Fungal Divers. 2013, 61, 1–27. [Google Scholar] [CrossRef]
- Overy, D.P.; Bayman, P.; Kerr, R.G.; Bills, G.F. An assessment of natural product discovery from marine (sensu strictu) and marine-derived fungi. Mycology 2014, 5, 145–167. [Google Scholar] [CrossRef] [PubMed]
- Flewelling, A.J.; Currie, J.; Gray, C.A.; Johnson, J.A. Endophytes from marine macroalgae: Promising sources of novel natural products. Curr. Sci. 2015, 109, 88–111. [Google Scholar]
- Miao, F.; Zuo, J.; Liu, X.; Ji, N. Algicidal activities of secondary metabolites of marine macroalgal-derived endophytic fungi. J. Oceanol. Limnol. 2019, 37, 112–121. [Google Scholar] [CrossRef]
- Gnavi, G.; Garzoli, L.; Poli, A.; Prigione, V.; Burgaud, G.; Varese, G.C. The culturable mycobiota of Flabellia petiolata: First survey of marine fungi associated to a Mediterranean green alga. PLoS ONE 2017, 12, e0175941. [Google Scholar] [CrossRef]
- Kohlmeyer, J.; Volkmann-Kohlmeyer, B. Illustrated key to the filamentous higher marine fungi. Bot. Mar. 1991, 34, 1–61. [Google Scholar] [CrossRef]
- Stanley, S.J. Observations on the seasonal occurrence of marine endophytic and parasitic fungi. Can. J. Bot. 1992, 70, 2089–2096. [Google Scholar] [CrossRef]
- Zuccaro, A.; Schoch, C.L.; Spatafora, J.W.; Kohlmeyer, J.; Draeger, S.; Mitchell, J.I. Detection and identification of fungi intimately associated with the brown seaweed Fucus serratus. Appl. Environ. Microbiol. 2008, 74, 931–941. [Google Scholar] [CrossRef] [PubMed]
- Lee, S.; Park, M.S.; Lee, H.; Kim, J.J.; Eimes, J.A.; Lim, Y.W. Fungal diversity and enzyme activity associated with the macroalgae, Agarum clathratum. Mycobiology 2019, 47, 50–58. [Google Scholar] [CrossRef] [PubMed]
- Zuccaro, A.; Summerbell, R.C.; Gams, W.; Schroers, H.-J.; Mitchell, J.I. A new Acremonium species associated with Fucus spp., and its affinity with a phylogenetically distinct marine Emericellopsis clade. Stud. Mycol. 2004, 50, 283–297. [Google Scholar]
- Kohlmeyer, J.; Kohlmeyer, E. Marine Mycology: The Higher Fungi; Elsevier: Amsterdam, The Netherlands, 2013. [Google Scholar]
- Wainwright, B.J.; Bauman, A.G.; Zahn, G.L.; Todd, P.A.; Huang, D. Characterization of fungal biodiversity and communities associated with the reef macroalga Sargassum ilicifolium reveals fungal community differentiation according to geographic locality and algal structure. Mar. Biodivers. 2019, 49, 2601–2608. [Google Scholar] [CrossRef]
- Mäkelä, M.R.; Donofrio, N.; de Vries, R.P. Plant biomass degradation by fungi. Fungal Genet. Biol. 2014, 72, 2–9. [Google Scholar] [CrossRef]
- Peterson, R.; Nevalainen, H. Trichoderma reesei RUT-C30–thirty years of strain improvement. Microbiology 2012, 158, 58–68. [Google Scholar] [CrossRef]
- De Vries, R.P.; Visser, J. Aspergillus enzymes involved in degradation of plant cell wall polysaccharides. Microbiol. Mol. Biol. Rev. 2001, 65, 497–522. [Google Scholar] [CrossRef]
- Wei, N.; Quarterman, J.; Jin, Y.-S. Marine macroalgae: An untapped resource for producing fuels and chemicals. Trends Biotechnol. 2013, 31, 70–77. [Google Scholar] [CrossRef]
- Gao, K.; McKinley, K.R. Use of macroalgae for marine biomass production and CO2 remediation: A review. J. Appl. Phycol. 1994, 6, 45–60. [Google Scholar] [CrossRef]
- John, R.P.; Anisha, G.; Nampoothiri, K.M.; Pandey, A. Micro and macroalgal biomass: A renewable source for bioethanol. Bioresour. Technol. 2011, 102, 186–193. [Google Scholar] [CrossRef]
- Balabanova, L.; Slepchenko, L.; Son, O.; Tekutyeva, L. Biotechnology potential of marine fungi degrading plant and algae polymeric substrates. Front. Microbiol. 2018, 9, 15–27. [Google Scholar] [CrossRef] [PubMed]
- Galagan, J.E.; Calvo, S.E.; Cuomo, C.; Ma, L.-J.; Wortman, J.R.; Batzoglou, S.; Lee, S.-I.; Baştürkmen, M.; Spevak, C.C.; Clutterbuck, J.; et al. Sequencing of Aspergillus nidulans and comparative analysis with A. fumigatus and A. oryzae. Nature 2005, 438, 1105–1115. [Google Scholar] [CrossRef] [PubMed]
- Ein-Gil, N.; Ilan, M.; Carmeli, S.; Smith, G.W.; Pawlik, J.R.; Yarden, O. Presence of Aspergillus sydowii, a pathogen of gorgonian sea fans in the marine sponge Spongia obscura. ISME J. 2009, 3, 752–755. [Google Scholar] [CrossRef]
- De Vries, R.P.; Burgers, K.; van de Vondervoort, P.J.; Frisvad, J.C.; Samson, R.A.; Visser, J. A new black Aspergillus species, A. vadensis, is a promising host for homologous and heterologous protein production. Appl. Environ. Microbiol. 2004, 70, 3954–3959. [Google Scholar] [CrossRef] [PubMed]
- De Hoog, G.S.; Gerrits van den Ende, A.H.G. Molecular diagnostics of clinical strains of filamentous Basidiomycetes. Mycoses 1998, 41, 183–189. [Google Scholar] [CrossRef]
- Vilgalys, R.; Hester, M. Rapid genetic identification and mapping of enzymatically amplified ribosomal DNA from several Cryptococcus species. J. Bacteriol. 1990, 172, 4238–4246. [Google Scholar] [CrossRef]
- Boekhout, T.; Theelen, B.; Houbraken, J.; Robert, V.; Scorzetti, G.; Gafni, A.; Gerson, U.; Sztejnberg, A. Novel anamorphic mite-associated fungi belonging to the Ustilaginomycetes: Meira geulakonigii gen. nov., sp. nov., Meira argovae sp. nov. and Acaromyces ingoldii gen. nov., sp. nov. Int. J. Syst. Evol. Microbiol. 2003, 53, 1655–1664. [Google Scholar] [CrossRef]
- Glass, N.L.; Donaldson, G.C. Development of primer sets designed for use with the PCR to amplify conserved genes from filamentous ascomycetes. Appl. Environ. Microbiol. 1995, 61, 1323–1330. [Google Scholar]
- Carbone, I.; Kohn, L.M. A method for designing primer sets for speciation studies in filamentous ascomycetes. Mycologia 1999, 91, 553–556. [Google Scholar] [CrossRef]
- Hong, S.-B.; Cho, H.-S.; Shin, H.-D.; Frisvad, J.C.; Samson, R.A. Novel Neosartorya species isolated from soil in Korea. Int. J. Syst. Evol. Microbiol. 2006, 56, 477–486. [Google Scholar] [CrossRef]
- Peterson, S.W.; Bayer, E.M.; Wicklow, D.T. Penicillium thiersii, Penicillium angulare and Penicillium decaturense, new species isolated from wood-decay fungi in North America and their phylogenetic placement from multilocus DNA sequence analysis. Mycologia 2004, 96, 1280–1293. [Google Scholar] [CrossRef] [PubMed]
- Groenewald, M.; Groenewald, J.Z.; Crous, P.W. Distinct species exist within the Cercospora apii morphotype. Phytopathology 2005, 95, 951–959. [Google Scholar] [CrossRef] [PubMed]
- White, T.J.; Bruns, T.; Lee, S.; Taylor, J. Amplification and direct sequencing of fungal ribosomal RNA genes for phylogenetics. In PCR Protocols: A Guide to Methods and Applications; Innis, M.A., Gelfand, D.H., Sninsky, J.J., White, T.J., Eds.; Academic Press: San Diego, CA, USA, 1990; Volume 18, pp. 315–322. [Google Scholar]
- Battaglia, E.; Benoit, I.; van den Brink, J.; Wiebenga, A.; Coutinho, P.M.; Henrissat, B.; de Vries, R.P. Carbohydrate-active enzymes from the zygomycete fungus Rhizopus oryzae: A highly specialized approach to carbohydrate degradation depicted at genome level. BMC Genom. 2011, 12, 38. [Google Scholar] [CrossRef] [PubMed]
- Ma, L.-J.; Ibrahim, A.S.; Skory, C.; Grabherr, M.G.; Burger, G.; Butler, M.; Elias, M.; Idnurm, A.; Lang, B.F.; Sone, T. Genomic analysis of the basal lineage fungus Rhizopus oryzae reveals a whole-genome duplication. PLoS Genet. 2009, 5, e1000549. [Google Scholar] [CrossRef]
- Xiao, Z.; Grosse, S.; Bergeron, H.; Lau, P.C. Cloning and characterization of the first GH10 and GH11 xylanases from Rhizopus oryzae. Appl. Microbiol. Biotechnol. 2014, 98, 8211–8222. [Google Scholar] [CrossRef]
- Flewelling, A.J.; Johnson, J.A.; Gray, C.A. Isolation and bioassay screening of fungal endophytes from North Atlantic marine macroalgae. Bot. Mar. 2013, 56, 287–297. [Google Scholar] [CrossRef]
- Panno, L.; Bruno, M.; Voyron, S.; Anastasi, A.; Gnavi, G.; Miserere, L.; Varese, G.C. Diversity, ecological role and potential biotechnological applications of marine fungi associated to the seagrass Posidonia oceanica. New Biotechnol. 2013, 30, 685–694. [Google Scholar] [CrossRef]
- Hamayun, M.; Afzal Khan, S.; Ahmad, N.; Tang, D.-S.; Kang, S.-M.; Na, C.-I.; Sohn, E.-Y.; Hwang, Y.-H.; Shin, D.-H.; Lee, B.-H.; et al. Cladosporium sphaerospermum as a new plant growth-promoting endophyte from the roots of Glycine max (L.) Merr. World J. Microbiol. Biotechnol. 2009, 25, 627–632. [Google Scholar] [CrossRef]
- Lorenzini, M.; Zapparoli, G. Occurrence and infection of Cladosporium, Fusarium, Epicoccum and Aureobasidium in withered rotten grapes during post-harvest dehydration. Antonie Van Leeuwenhoek 2015, 108, 1171–1180. [Google Scholar] [CrossRef]
- Overy, D.P.; Frisvad, J.C. Mycotoxin production and postharvest storage rot of ginger (Zingiber officinale) by Penicillium brevicompactum. J. Food Prot. 2005, 68, 607–609. [Google Scholar] [CrossRef]
- Zhai, M.-M.; Qi, F.-M.; Li, J.; Jiang, C.-X.; Hou, Y.; Shi, Y.-P.; Di, D.-L.; Zhang, J.-W.; Wu, Q.-X. Isolation of secondary metabolites from the soil-derived fungus Clonostachys rosea YRS-06, a biological control agent, and evaluation of antibacterial activity. J. Agric. Food Chem. 2016, 64, 2298–2306. [Google Scholar] [CrossRef] [PubMed]
- Hiol, A.; Jonzo, M.D.; Rugani, N.; Druet, D.; Sarda, L.; Comeau, L.C. Purification and characterization of an extracellular lipase from a thermophilic Rhizopus oryzae strain isolated from palm fruit. Enzym. Microb. Technol. 2000, 26, 421–430. [Google Scholar] [CrossRef]
- Wu, G.; Sun, X.; Yu, G.; Wang, W.; Zhu, T.; Gu, Q.; Li, D. Cladosins A–E, hybrid polyketides from a deep-sea-derived fungus, Cladosporium sphaerospermum. J. Nat. Prod. 2014, 77, 270–275. [Google Scholar] [CrossRef] [PubMed]
- Oren, A.; Gunde-Cimerman, N. Fungal life in the Dead Sea. In Biology of Marine Fungi; Springer: Berlin, Germany, 2012; pp. 115–132. [Google Scholar]
- Dias, A.C.D.S.; Ruiz, N.; Couzinet-Mossion, A.; Bertrand, S.; Duflos, M.; Pouchus, Y.-F.; Barnathan, G.; Nazih, H.; Wielgosz-Collin, G. The marine-derived fungus Clonostachys rosea, source of a rare conjugated 4-Me-6E, 8E-hexadecadienoic acid reducing viability of MCF-7 breast cancer cells and gene expression of lipogenic enzymes. Mar. Drugs 2015, 13, 4934–4948. [Google Scholar] [CrossRef]
- Sun, H.-H.; Mao, W.-J.; Jiao, J.-Y.; Xu, J.-C.; Li, H.-Y.; Chen, Y.; Qi, X.-H.; Chen, Y.-L.; Xu, J.; Zhao, C.-Q.; et al. Structural characterization of extracellular polysaccharides produced by the marine fungus Epicoccum nigrum JJY-40 and their antioxidant activities. Mar. Biotechnol. 2011, 13, 1048–1055. [Google Scholar] [CrossRef]
- Paz, Z.; Komon-Zelazowska, M.; Druzhinina, I.S.; Aveskamp, M.M.; Shnaiderman, A.; Aluma, Y.; Carmeli, S.; Ilan, M.; Yarden, O. Diversity and potential antifungal properties of fungi associated with a Mediterranean sponge. Fungal Divers. 2010, 42, 17–26. [Google Scholar] [CrossRef]
- Wang, F.; Fang, Y.; Zhang, M.; Lin, A.; Zhu, T.; Gu, Q.; Zhu, W. Six new ergosterols from the marine-derived fungus Rhizopus sp. Steroids 2008, 73, 19–26. [Google Scholar] [CrossRef]
- Pasqualetti, M.; Barghini, P.; Giovannini, V.; Fenice, M. High production of chitinolytic activity in halophilic conditions by a new marine strain of Clonostachys rosea. Molecules 2019, 24, 1880. [Google Scholar] [CrossRef]
- Sun, Y.; Tian, L.; Huang, J.; Ma, H.-Y.; Zheng, Z.; Lv, A.-L.; Yasukawa, K.; Pei, Y.-H. Trichodermatides A−D, novel polyketides from the marine-derived fungus Trichoderma reesei. Org. Lett. 2008, 10, 393–396. [Google Scholar] [CrossRef]
- Pruksakorn, P.; Arai, M.; Kotoku, N.; Vilchèze, C.; Baughn, A.D.; Moodley, P.; Jacobs, W.R., Jr.; Kobayashi, M. Trichoderins, novel aminolipopeptides from a marine sponge-derived Trichoderma sp., are active against dormant mycobacteria. Bioorg. Med. Chem. Lett. 2010, 20, 3658–3663. [Google Scholar] [CrossRef]
- Garzoli, L.; Poli, A.; Prigione, V.; Gnavi, G.; Varese, G.C. Peacock’s tail with a fungal cocktail: First assessment of the mycobiota associated with the brown alga Padina pavonica. Fungal Ecol. 2018, 35, 87–97. [Google Scholar] [CrossRef]
- Brown, N.A.; Ries, L.N.A.; Goldman, G.H. How nutritional status signalling coordinates metabolism and lignocellulolytic enzyme secretion. Fungal Genet. Biol. 2014, 72, 48–63. [Google Scholar] [CrossRef] [PubMed]
- Cong, B.; Wang, N.; Liu, S.; Liu, F.; Yin, X.; Shen, J. Isolation, characterization and transcriptome analysis of a novel Antarctic Aspergillus sydowii strain MS-19 as a potential lignocellulosic enzyme source. BMC Microbiol. 2017, 17, 1–14. [Google Scholar] [CrossRef] [PubMed]
- Oliveira, M.d.S.; Feddern, V.; Kupski, L.; Cipolatti, E.; Badiale-Furlong, E.; de Souza-Soares, L. Physico-chemical characterization of fermented rice bran biomass. CyTA-J. Food 2010, 8, 229–236. [Google Scholar]
- Osono, T.; Fukasawa, Y.; Takeda, H. Roles of diverse fungi in larch needle-litter decomposition. Mycologia 2003, 95, 820–826. [Google Scholar] [CrossRef]
- Blaszczyk, L.; Strakowska, J.; Chelkowski, J.; Gabka-Buszek, A.; Kaczmarek, J. Trichoderma species occurring on wood with decay symptoms in mountain forests in Central Europe: Genetic and enzymatic characterization. J. Appl. Genet. 2016, 57, 397–407. [Google Scholar] [CrossRef]
- Kim, D.; Orrego, D.; Ximenes, E.A.; Ladisch, M.R. Cellulose conversion of corn pericarp without pretreatment. Bioresour. Technol. 2017, 245, 511–517. [Google Scholar] [CrossRef]
- Dien, B.S.; Miller, D.J.; Hector, R.E.; Dixon, R.A.; Chen, F.; McCaslin, M.; Reisen, P.; Sarath, G.; Cotta, M.A. Enhancing alfalfa conversion efficiencies for sugar recovery and ethanol production by altering lignin composition. Bioresour. Technol. 2011, 102, 6479–6486. [Google Scholar] [CrossRef]
- Neethu, K.; Rubeena, M.; Sajith, S.; Sreedevi, S.; Priji, P.; Unni, K.; Josh, M.S.; Jisha, V.; Pradeep, S.; Benjamin, S. A novel strain of Trichoderma viride shows complete lignocellulolytic activities. Adv. Biosci. Biotechnol. 2012, 3, 1160. [Google Scholar] [CrossRef]
- Van den Brink, J.; Maitan-Alfenas, G.P.; Zou, G.; Wang, C.; Zhou, Z.; Guimarães, V.M.; de Vries, R.P. Synergistic effect of Aspergillus niger and Trichoderma reesei enzyme sets on the saccharification of wheat straw and sugarcane bagasse. Biotechnol. J. 2014, 9, 1329–1338. [Google Scholar] [CrossRef]

| Species | Collection No. 1 | GenBank Accession No. | |||||
|---|---|---|---|---|---|---|---|
| ITS | LSU | ACT | CMD | TEF | Btub | ||
| Cladosporium ramotenellum | CBS 143784 FP-027-A6 | MH102075 | MH102097 | MH102066 | MH102119 | ||
| Penicillium brevicompactum | CBS 143785 FP-027-A8 | MH102076 | MH102098 | MH102074 | MH102072 | ||
| Clonostachys rosea | CBS 143783 FP-027-A3 | MH102077 | MH102099 | MH102067 | MH102120 | MH102073 | |
| Cladosporium europaeum | CBS 143786 FP-027-A9 | MH102078 | MH102100 | MH102068 | MH102121 | ||
| Rhizopus oryzae | CBS 143788 FP-027-B4 | MH102079 | MH102101 | ||||
| Cladosporium ramotenellum | CBS 143787 FP-027-B3 | MH102080 | MH102102 | MH102069 | |||
| Epicoccum nigrum | CBS 143789 FP-027-C2 | MH102081 | MH102103 | MH102070 | MH102122 | ||
| Trichoderma paraviridescens | CBS 143790 FP-027-C5 | MH102082 | MH102104 | MH102123 | |||
| Cladosporium sphaerospermum | CBS 143782 FP-027-A1 | MH102083 | MH102105 | MH102071 | MH102124 | ||
| Aspergillus sp. | FP-027-B1 | MH102084 | MH102106 | ||||
| Penicillium sp. | FP-027-A5 | MH102085 | MH102107 | ||||
| Penicillium sp. | FP-027-A4 | MH102086 | MH102108 | ||||
| Penicillium sp. | FP-027-A7 | MH102087 | MH102109 | ||||
| Alternaria sp. | FP-027-B2 | MH102088 | MH102110 | ||||
| Engyodontium sp. | FP-027-C4 | MH102089 | MH102111 | ||||
| Engyodontium sp. | FP-027-B9 | MH102090 | MH102112 | ||||
| Exophiala sp. | FP-027-C6 | MH102091 | MH102113 | ||||
| Cladosporium sp. | FP-027-A2 | MH102092 | MH102114 | ||||
| Alternaria sp. | FP-027-D2 | MH102093 | MH102115 | ||||
| Symmetrospora sp. | FP-027-B6 | MH102094 | MH102116 | ||||
| Cryptococcus sp. | FP-027-B7 | MH102095 | MH102117 | ||||
| Leucosporidium sp. | FP-027-B5 | MH102096 | MH102118 | ||||
© 2019 by the authors. Licensee MDPI, Basel, Switzerland. This article is an open access article distributed under the terms and conditions of the Creative Commons Attribution (CC BY) license (http://creativecommons.org/licenses/by/4.0/).
Share and Cite
Patyshakuliyeva, A.; Falkoski, D.L.; Wiebenga, A.; Timmermans, K.; de Vries, R.P. Macroalgae Derived Fungi Have High Abilities to Degrade Algal Polymers. Microorganisms 2020, 8, 52. https://doi.org/10.3390/microorganisms8010052
Patyshakuliyeva A, Falkoski DL, Wiebenga A, Timmermans K, de Vries RP. Macroalgae Derived Fungi Have High Abilities to Degrade Algal Polymers. Microorganisms. 2020; 8(1):52. https://doi.org/10.3390/microorganisms8010052
Chicago/Turabian StylePatyshakuliyeva, Aleksandrina, Daniel L. Falkoski, Ad Wiebenga, Klaas Timmermans, and Ronald P. de Vries. 2020. "Macroalgae Derived Fungi Have High Abilities to Degrade Algal Polymers" Microorganisms 8, no. 1: 52. https://doi.org/10.3390/microorganisms8010052
APA StylePatyshakuliyeva, A., Falkoski, D. L., Wiebenga, A., Timmermans, K., & de Vries, R. P. (2020). Macroalgae Derived Fungi Have High Abilities to Degrade Algal Polymers. Microorganisms, 8(1), 52. https://doi.org/10.3390/microorganisms8010052

